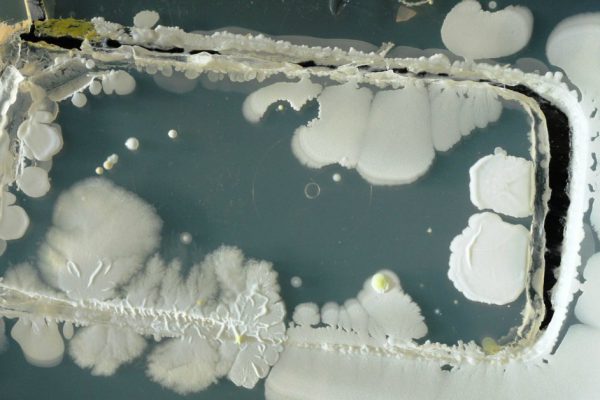
Шокирующая правда о том, сколько микробов накапливает мобильный телефон!

Разнообразие косметических брендов в магазинах просто зашкаливает. Все они предлагают интересную продукцию, которую так и хочется приобрести в свою косметичку. И даже если ты ничего не намерена покупать, протестировать всю эту красоту всё равно захочется. Но задумывалась ты когда-либо о […]
Метка: Бактерии
Ты наверняка пользовалась гигиеническими прокладками неправильно! Маленькое открытие.
Первые прокладки появились в 1970-х годах, и даже не хочется думать, как женщины справлялись с особенностями своей физиологии до их появления. Ужас-ужас: пояс с пуговицами, который удерживал прокладку из ткани, резиновые детали трусиков, марлевые прокладки… Использовать гигиенические прокладки — дело […]
Осторожно! Нынче в общественном транспорте гуляют страшные инфекции… Защити себя!
Жизнь в городе сопряжена со множеством опасностей, и одна из главных – инфекции. В холодное время года любой, кто оказался в транспорте — потенциальная жертва ОРВИ, а туберкулез вообще опасность внесезонная. Но так ли всё страшно, как об этом повсюду […]
«Японская матка»! Вот почему тысячи японок пьют настой чайного гриба в обязательном порядке.
Года 2 назад увидела банку с чайным грибом у своего друга на кухне. Он угостил меня прохладным, терпковатым напитком. Далекое воспоминание из детства, вкус, который ни с чем не перепутаешь! Удивилась, конечно, что он является счастливым обладателем такого чуда, но […]
Прочитав нашу статью, ты больше никогда не возьмешь с собой телефон в дамскую комнату!
Вредные привычки формируются куда быстрее и легче, чем полезные! «Мы являемся тем, что постоянно делаем. Совершенство, следовательно, не действие, а привычка». Так считал Аристотель, и я восхищаюсь этими мудрыми словами. Привычка находиться в туалете с телефоном требует твоего пристального внимания. […]
Врачи предупреждают женщин всего мира, чтобы те прекратили пользоваться мочалками!
Что может лучше снять стресс и одновременно тонизировать организм, чем душ (а лучше ванна) с массажем любимой мочалкой! Вот только врачи-дерматологи с этим не спешат соглашаться, потому что этой самой мочалкой можно принести себе больше вреда, чем пользы. Мочалки для […]
Шокирующая правда о том, сколько микробов накапливает мобильный телефон!
Сложно представить жизнь без мобильных устройств. Они стали нашими надежными помощниками в поддержании связи с окружающим миром, планировании задач, самовыражении, развлечениях… К сожалению, мало кто задумывается, сколько бактерий живет на корпусе любимого гаджета. А ведь многие из них — болезнетворные! […]
Как вылечить стоматит в домашних условиях: средство, которое работает безотказно.
Стоматит — поражение слизистой полости рта, выраженное в виде болезненных язвочек на языке, щеках, деснах… С этим заболеванием человек может столкнуться в любом возрасте, и причины его также могут быть разные: от обычной травмы слизистой и несоблюдения гигиены до скрытых […]
Золотистый стафилококк: лечение народными средствами
Метициллин-резистентный золотистый стафилококк (МРЗС) — это штамм патогенных бактерий, устойчивых к основным антибиотикам. В том числе к метициллину, оксациллину, пенициллину, амоксициллину. Сегодняшняя тема для разговора: золотистый стафилококк и лечение народными средствами. Как правило, эта бактерия живет на кожных покровах человека, […]
То, чего никогда не расскажет гинеколог: продукт, уничтожающий грибок, бактерии и неприятный запах.
Рано или поздно любая женщина вынуждена обращаться к врачу с симптомами, о которых ей неловко говорить. Покраснение, зуд половых органов, распухание слизистой, боль внизу живота, дурно пахнущие выделения… Вагинит — воспаление слизистой влагалища, спровоцированное болезнетворными бактериями или грибками. По статистике, […]
Мытье рук больше никогда не будет прежним! Ужасающий эксперимент…
Мы можем считать, что тщательно вымыли руки и видеть, что они чистые. Но очень часто это — опасное заблуждение, которое становится причиной различных заболеваний. Микробы на руках исчезают только в одном случае! Журналисты издания «The Daily Mail» провели эксперимент, результаты […]
Теперь ты никогда не застелешь сиденье унитаза туалетной бумагой!
В общественных туалетах, даже в относительно чистых, по понятным причинам сложно не поддаться чувству брезгливости. Но, как говорится, когда приспичит, выбора не остается! Решение застелить сиденье унитаза туалетной бумагой, чтобы защитить себя от микробов кажется очевидным, но реальность куда суровей, […]
Лучший врач: «Слезно молю! Прекращай выбрасывать гранатовые корки. Возьми воду…»
Говоря о пользе граната, как правило, мы имеем в виду зерна или сок. И мало кто догадывается, что даже корки этих удивительных плодов обладают лечебными свойствами! Гранатовые корки Гранатовые корки — это то, что должно быть в каждой домашней аптечке. […]
Напиток здоровья древних греков: незабываемый вкус, волшебный аромат и колоссальная польза!
Чабрец еще называют тимьяном, а в народе — богородской травой. Это уникальное растение известно человеку с незапамятных времен. Ценят его преимущественно за неповторимый аромат и сильнейшие лекарственные свойства. Чабрец обладает бактерицидными, ранозаживляющими, обезболивающими, отхаркивающими, бронхорасширяющими, противоглистными и многими другими свойствами. […]
Теперь я не делаю этого перед сном! Узнав причину, ты тоже многое изменишь…
С детства меня приучали спать в ночной рубашке, пижаме или нижнем белье. Мне даже не приходила в голову мысль, что можно иначе! Пару месяцев назад я попала на прием к гинекологу, и он порекомендовал мне спать без нижнего белья. Врач […]
Эта женщина прятала зубчик чеснока под подушку своего сына каждую ночь… Причина проста!
Когда-то чеснок использовали в качестве амулета против вампиров, оборотней, ведьм и злых духов. Связки чеснока висели у входа в дом, и хозяевам было спокойно на душе… Чеснок и правда обладает мощным защитным действием! Бактерии, вирусы, любые болезнетворные микроорганизмы, которые становятся […]
Медики побледнели! Здоровье будет, как в 20 лет, нужно только не забывать…
Лучшая профилактика различных инфекций мочеполовой системы — сбалансированное питание! Оказывается, продукты, которые мы едим, влияют на состояние микрофлоры влагалища. Если в женский организм поступает недостаточное количество определенных полезных веществ, риск возникновения молочницы увеличивается в 3 раза! Натуральные пробиотики и витамины: […]
Когда врач увидел зубы 3-летнего ребенка, он задал матери всего один вопрос…
Более 93 % людей разного возраста страдает от кариеса зубов! Мы знаем об этом заболевании очень много, но вместе с тем недостаточно… Чтобы у взрослого человека не возникло кариеса, нужно проводить профилактику еще в детстве. К сожалению, одной регулярной чисткой […]